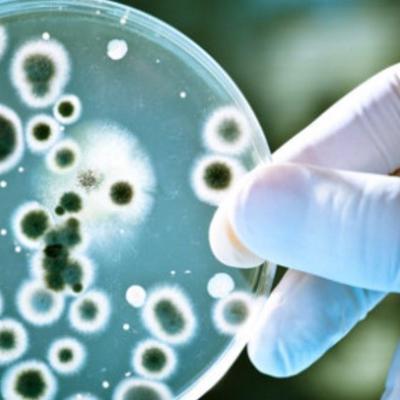
Main mikrob esas 44

На МКС обнаружены микроорганизмы
Ученые изучают бактерии собранные на поверхности российского сегмента Международной космической станции. Образцы были собраны в рамках космического эксперимента "Тест" с 2010-го по 2016 год. В более ранних образцах были обнаружены жизнеспособные споры земных бактерий. Теперь же обнаружены и сами микроорганизмы. По словам космонавта Антона Шкаплерова, не исключено, что это были земные бактерии, которые выдержали жестокие условия космоса в течение несколько лет. Это очень любопытная информация, рассказал в эфире радио Sputnik почетный вице-президент Российской Академии естественных наук Виктор Зуев.
«В рамках космического эксперимента "Тест" во время выходов в космос с борта МКС по российской программе космонавты берут ватными тампонами мазки с внешней поверхности станции. В частности, пробы берутся в месте скопления отходов топлива, выбрасываемых при работе двигателей, или в местах, где поверхность станции более затемнена. Добытые образцы доставляются на Землю, где их изучают специалисты. В мае «Роскосмос» сообщал об обнаружении на поверхности МКС жизнеспособных спор земных микроорганизмов. И вот теперь в пробах обнаружены сами бактерии. Учитывая условия, в которых они видимо, смогли выжить, это действительно важный факт. МКС подвергнута действиям всех тех неблагоприятных факторов, от которых человек, прежде всего, должен защищаться, и защищается массой всяких средств. А бактерии находятся на поверхности. Они не защищены, и, тем не менее, они выжили. Этот сам по себе факт очень любопытный. Интересно теперь посмотреть свойства этих бактерий», - отметил ученый.
Нельзя исключать и внеземное происхождение бактерий, уверен футуролог, член Ассоциации футурологов Александр Кононов.
«Результаты исследований были встречены неоднозначно научным сообществом. Критики отметили, что размеры найденных образований в 100-1000 раз меньше типичных земных бактерий, и их объём слишком мал для размещения в нём молекул ДНК и РНК. В ходе последующих исследований в образцах были обнаружены следы земных биозагрязнений. Большая часть научного сообщества все-таки склоняется к мысли, что встреча с инопланетными формами жизни если и произойдет, то это будет не скоро. Хотя готовиться к этому необходимо заранее. Конечно, это очень важное открытие. Но на самом деле оно вскрывает очень важную проблему, которая сейчас существует, потому что у нас нет возможности проводить такого рода исследования, где-то обособленно, подальше от Земли. Насколько они опасные или неопасные эти бактерии, нам нужны санитарные кордоны. Хорошим санитарным кордоном могла бы стать например, Луна», - предположил футуролог.
https://ria.ru/radio/
Для справки:
Радио Sputnik - информационно-аналитическая радиостанция с круглосуточным вещанием: новости и эксклюзивные интервью, авторские программы по вопросам политики и экономики в России и за рубежом, мнения экспертов по наиболее актуальным темам, аналитические комментарии к событиям. Радио Sputnik создано 10 ноября 2014 года. В настоящее время вещает на современных цифровых платформах и доступно в FM-диапазоне и в сети интернет. Русскоязычное вещание радио Sputnik является частью глобальной радиовещательной сети международного информационного агентства и радио Sputnik, представленного в десятках стран мира.